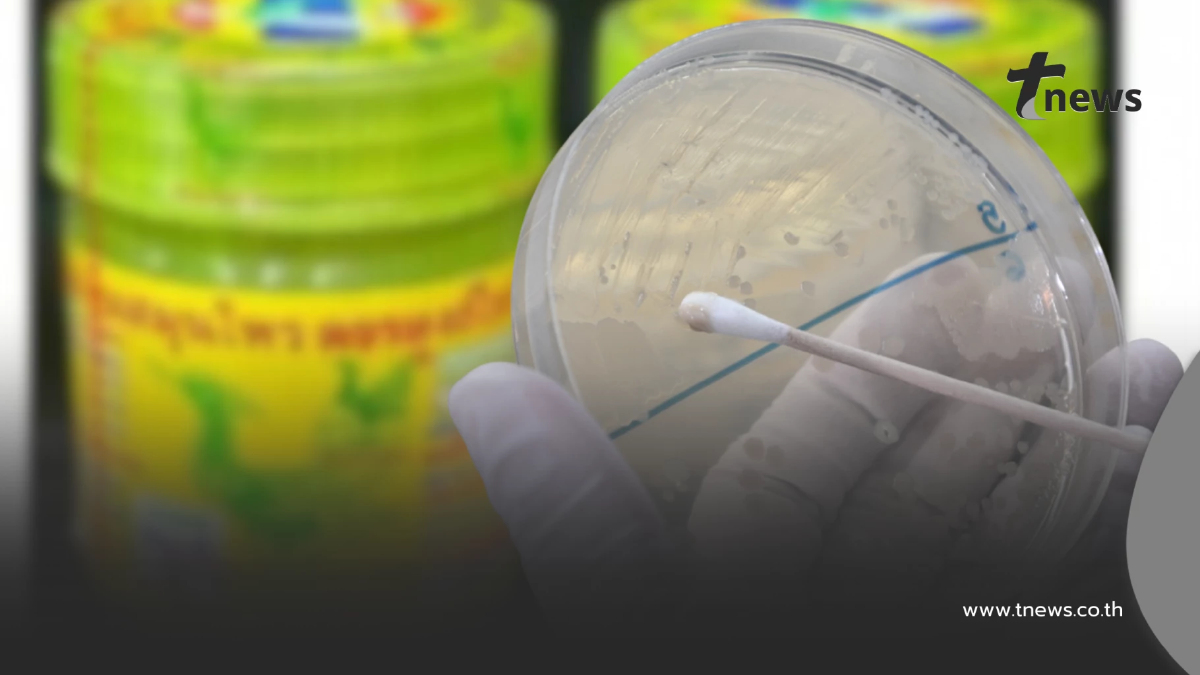
กรมวิทยาศาสตร์การแพทย์ เผยชัดแล้ว ผลตรวจยาดมสมุนไพร "หงส์ไทย"

- 29 ต.ค. 2568
กรมวิทยาศาสตร์การแพทย์ เปิดผลตรวจยาดมสมุนไพร ตราหงส์ไทย สูตร 2 ยืนยันพบเป็นเชื้อคลอสตริเดียม เพอร์ฟริงเจนส์
เมื่อวันที่ 28 ต.ค. 2568 ดร.นพ.สราวุฒิ บุญสุข อธิบดีกรมวิทยาศาสตร์การแพทย์ เปิดเผยว่า กรณีที่สำนักงานคณะกรรมการอาหารและยา (อย.) ได้เก็บตัวอย่างยาดมสมุนไพร ตราหงส์ไทย เลขทะเบียน G 309/62 รุ่นการผลิต 000332 ว่า กรมวิทยาศาสตร์การแพทย์ ได้รับตัวอย่างยาดมสมุนไพร ตราหงส์ไทย สูตร 2 จาก อย. จำนวน 2 ครั้ง ครั้งที่ 1 ส่งตรวจเดือนมิถุนายน รายงานผลกรกฎาคม ครั้งที่ 2 ส่งตรวจเดือนสิงหาคม รายงานผลกันยายน ผลตรวจพบผิดมาตรฐานในหัวข้อจำนวนเชื้อจุลินทรีย์ที่เจริญเติบโตในอากาศทั้งหมด จำนวนรวมของยีสต์และรา และพบการปนเปื้อนเชื้อคลอสตริเดียม (Clostridium spp.) ซึ่งจากการตรวจยืนยัน พบเป็น เชื้อคลอสตริเดียม เพอร์ฟริงเจนส์ (Clostridium perfringens)
ดร.นพ.สราวุฒิ กล่าวต่ออีกว่า สำหรับวิธีการตรวจนั้น กรมวิทยาศาสตร์การแพทย์ โดยสำนักยาและวัตถุเสพติด ดำเนินการตรวจโดยวิธีมาตรฐานตำรายาบริติชฟาร์มาโคเปีย(British Pharmacopoeia) และตำรามาตรฐานยาสมุนไพรไทย (Thai Herbal Pharmacopoeia) และใช้ข้อกำหนดเกณฑ์มาตรฐานตามประกาศกระทรวงสาธารณสุข เรื่อง เกณฑ์มาตรฐาน ค่าความบริสุทธิ์ หรือคุณลักษณะอื่นอันมีความสำคัญต่อคุณภาพ สำหรับตำรับผลิตภัณฑ์สมุนไพรที่ขึ้นทะเบียน แจ้งรายละเอียด หรือจดแจ้ง พ.ศ.2564
การตรวจการปนเปื้อนเชื้อจุลินทรีย์ ประกอบด้วย
- จำนวนเชื้อจุลินทรีย์ที่เจริญเติบโตในอากาศทั้งหมด ต้องไม่เกิน 200 โคโลนี/กรัม
- จำนวนรวมของยีสต์และรา ต้องไม่เกิน 20 โคโลนี/กรัม
- จุลินทรีย์เฉพาะ ต้องไม่พบเชื้อจุลินทรีย์สแตปฟิโลค็อคคัส ออเรียส เชื้อซูโดโมแนสแอรูจิโนซา และเชื้อคลอสตริเดียม
โดยวิธีการตรวจหาจำนวนเชื้อจุลินทรีย์ที่เจริญเติบโตในอากาศทั้งหมด และจำนวนรวมของยีสต์และรา ใช้วิธี Plate count ซึ่งเป็นการเพาะเลี้ยงเชื้อที่ปนเปื้อนในตัวอย่างบนจานเพาะเลี้ยงเชื้อ แล้วนับจำนวนเชื้อจุลินทรีย์ที่เจริญบนจานอาหารเลี้ยงเชื้อ
ส่วนการตรวจหาเชื้อจุลินทรีย์เฉพาะ ใช้วิธีการเพิ่มจำนวนเชื้อในอาหารเลี้ยงเชื้อเหลว และแยกด้วยอาหารเลี้ยงเชื้อเฉพาะสำหรับเชื้อแต่ละชนิด ทำการย้อมสีและดูลักษณะภาพใต้กล้องจุลทรรศน์
อธิบดีกรมวิทยาศาสตร์การแพทย์ กล่าวต่ออีกว่า ในปีงบประมาณพ.ศ. 2568 มีผลิตภัณฑ์ยาดมส่งตรวจที่สำนักยาและวัตถุเสพติด กรมวิทยาศาสตร์การแพทย์ จำนวน 54 ตัวอย่าง พบผิดมาตรฐาน 39 ตัวอย่าง ซึ่งส่วนใหญ่จะผิดมาตรฐานในเรื่อง จำนวนรวมของจุลินทรีย์ที่เจริญเติบโตโดยใช้อากาศ จำนวนรวมของยีสต์และรา และเชื้อคลอสตริเดียม (Clostridium spp.) จากการตรวจยืนยัน พบเป็นเชื้อคลอสตริเดียมเพอร์ฟริงเจนส์ ซึ่งกรมได้แจ้งหน่วยงานที่เกี่ยวข้องดำเนินการต่อไปแล้ว
ดร.นพ.สราวุฒิ กล่าวอีกว่า “เชื้อคลอสตริเดียม เพอร์ฟริงเจนส์ สามารถพบได้ทั่วไปในดิน เป็นเชื้อที่เจริญเติบโตได้ในสภาวะไร้ออกซิเจน ทั้งนี้ผู้มีร่างกายอ่อนแอ ภูมิคุ้มกันต่ำ หรือผู้สูงอายุ หากสูดดมอาจได้รับอันตรายจากสปอร์ของเชื้อราและเชื้อคลอสตริเดียม เพอร์ฟริงเจนส์ ซึ่งอาจมีผลกระทบต่อระบบทางเดินหายใจ เช่น หายใจลำบาก มีเสียงหวีดและอาการไอ ปวดปากและลำคอ นอกจากนี้อาจมีเลือดปนในน้ำลายและเสมหะได้ ดังนั้น ผู้ผลิตควรมีการกำจัดหรือลดปริมาณเชื้อจุลินทรีย์ก่อนนำมาผลิตเป็นผลิตภัณฑ์สมุนไพร เช่น การล้าง อบ หรือการฉายรังสี เพื่อความมั่นใจกรมวิทยาศาสตร์การแพทย์พร้อมสนับสนุนกลุ่มผู้ผลิตรายย่อยในการตรวจสอบคุณภาพก่อนจดทะเบียน เพื่อให้ได้ผลิตภัณฑ์ที่มีคุณภาพและปลอดภัยกับผู้บริโภค”